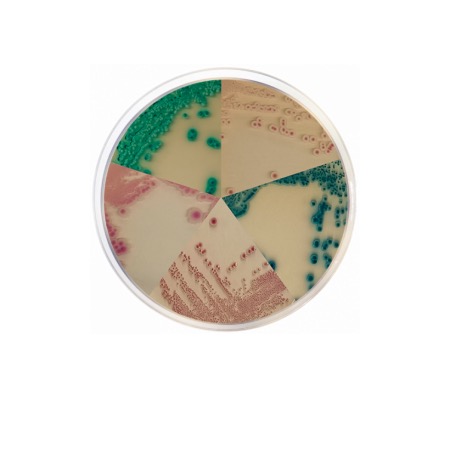
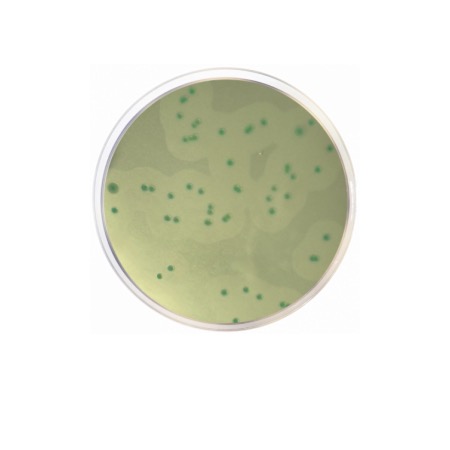
product
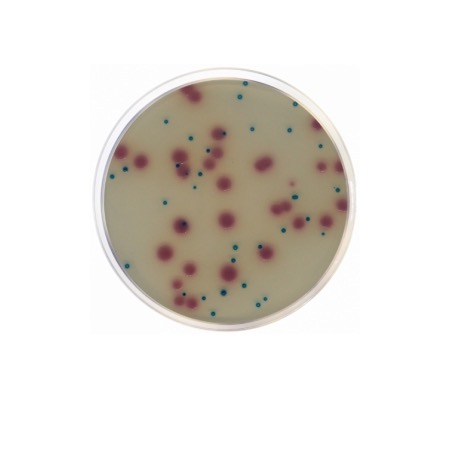
product

Candida Chromogenic Agar is a dehydrated chromogenic medium designed for selective isolation and differentiation of clinically and industrially relevant Candida species. The medium contains chromogenic substrates that react with species-specific enzymes, producing characteristic colony colors. It enables rapid presumptive identification of Candida spp. directly on primary isolation plates, reducing the need for additional biochemical tests.
Candida Chromogenic Agar (catalogue No. 2207) is a selective and differential culture medium intended for the isolation and presumptive identification of Candida species from clinical, food and environmental samples. The formulation includes peptones for nutritional support, selective agents to inhibit bacterial growth, and chromogenic substrates that are cleaved by species-specific enzymes produced by different Candida spp.
Following incubation, Candida species develop colonies with distinct colors and morphologies, allowing rapid visual differentiation. Typical reactions include green, blue, pink or cream-colored colonies depending on the species. This medium is widely used in routine diagnostics and quality control laboratories for screening and preliminary identification of Candida.
Advantages
- Rapid presumptive identification of Candida species based on colony color.
- Chromogenic differentiation reduces need for additional confirmatory tests.
- Selective inhibition of bacterial background flora.
- Suitable for clinical diagnostics, food testing and quality control laboratories.
Technical specifications
| Pack size | 500 g |
| Intended use | Selective isolation and presumptive identification of Candida species |
| Detection principle | Chromogenic enzyme substrates producing species-specific colony colors |
| Typical incubation | 35–37 °C, 24–48 h, aerobic |
| Application industry | Clinical diagnostics, food microbiology, quality control |
| Storage conditions | 2–25 °C, dry place, tightly closed |
| Chemical type | Microbial Culture Media |
| Brand | Condalab |
| Pack size | 500 g |